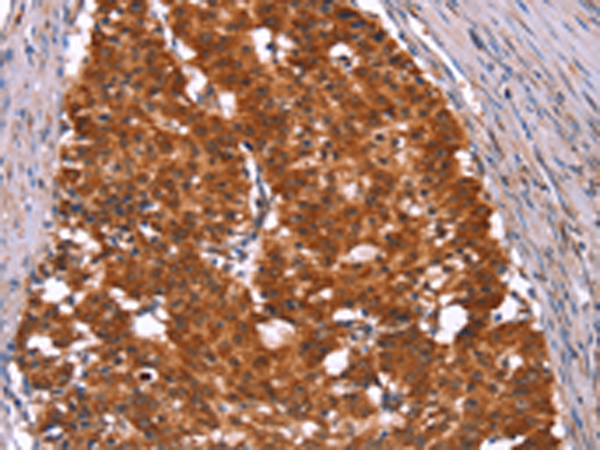
一抗

中文名稱: 兔抗HINT1多克隆抗體
宿 主: Rabbit
抗 原: HINT1
反應(yīng)種屬: Human, Mouse, Rat
標(biāo) 記 物: Unconjugate
技術(shù)規(guī)格
|
Background: |
The protein encoded by this gene can hydrolyze substrates such as AMP-morpholidate, AMP-N-alanine methyl ester, AMP-alpha-acetyl lysine methyl ester, and AMP-NH2. The encoded protein interacts with these substrates via a histidine triad motif, which is part of the loop that binds to the substrate. This gene has been found to be a tumor suppressing gene. Several transcript variants, but only one of them protein-coding, have been found for this gene. |
|
Applications: |
ELISA, WB, IHC |
|
Name of antibody: |
HINT1 |
|
Immunogen: |
Synthetic peptide of human HINT1 |
|
Full name: |
histidine triad nucleotide binding protein 1 |
|
Synonyms: |
HINT; NMAN; PKCI-1; PRKCNH1 |
|
SwissProt: |
P49773 |
|
IHC positive control: |
Human gastric cancer and human thyroid cancer |
|
IHC Recommend dilution: |
100-300 |
|
WB Predicted band size: |
14 kDa |
|
WB Positive control: |
LoVo cells |
|
WB Recommended dilution: |
500-2000 |




 購(gòu)物車
購(gòu)物車 幫助
幫助
 021-54845833/15800441009
021-54845833/15800441009